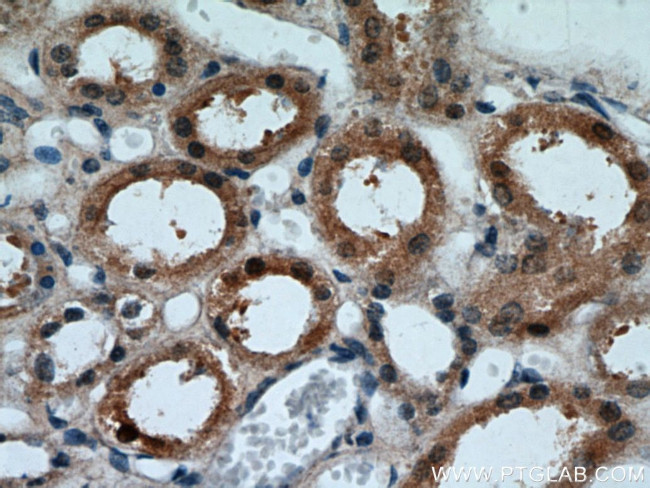
FOXO4 Antibody in Immunohistochemistry (Paraffin) (IHC (P))

Search
Proteintech
FOXO4 Polyclonal Antibody
{{$productOrderCtrl.translations['antibody.pdp.commerceCard.promotion.promotions']}}
{{$productOrderCtrl.translations['antibody.pdp.commerceCard.promotion.viewpromo']}}
{{$productOrderCtrl.translations['antibody.pdp.commerceCard.promotion.promocode']}}: {{promo.promoCode}} {{promo.promoTitle}} {{promo.promoDescription}}. {{$productOrderCtrl.translations['antibody.pdp.commerceCard.promotion.learnmore']}}
产品信息
21535-1-AP
种属反应
已发表种属
宿主/亚型
分类
类型
抗原
偶联物
形式
浓度
规格
纯化类型
保存液
内含物
保存条件
运输条件
产品详细信息
Immunogen sequence: MDSSSKLLR GRSKAPKKKP SVLPAPPEGA TPTSPVGHFA KWSGSPCSRN REEADMWTTF RPRSSSNASS VSTRLSPLRP ESEVLAEEIP ASVSSYAGGV PPTLNEGLEL LDGLNLTSSH SLLSRSGLSG FSLQHPGVTG PLHTYSSSLF SPAEGPLSAG EGCFSSSQAL EALLTSDTPP PPADVLMTQV DPILSQAPTL LLLGGLPSSS KLATGVGLCP KPLEAPGPSS LVPTLSMIAP PPVMASAPIP KALGTPVLTP PTEAASQDRM PQDLDLDMYM ENLECDMDNI ISDLMDEGEG LDFNFEPDP (198-505 aa encoded by BC106761)
靶标信息
FOXO4 (Forkhead box O4) is encoded by the FOXO4 gene located on the X chromosome. It is also known as AFX1 or MLLT7 (Myeloid/Lymphoid or Mixed-Lineage Leukemia (Trithorax Homolog, Translocated To, 7) and is a member of the O class of forkhead/ winged helix family of transcription factors along with FOXO1, FOXO3 and FOXO6. FOXO4 is abundantly expressed in skeletal muscle and adipose tissue. FOXO4 binds to the Insulin Responsive Element (IRE) and activates downstream targets of Insulin/IGF1 signaling such as IGFBP1. However, the activation of another downstream target of the Insulin/IGF1 pathway, Akt, leads to phosphorylation of FOXO4 on specific Ser/Thr residues. This phosphorylation mediates binding of FOXO4 to 14-3-3 and eventual exit of FOXO4 from the nucleus.
仅用于科研。不用于诊断过程。未经明确授权不得转售。
生物信息学
蛋白别名: AFX; AFX1; Afxh; AFXzeta; Fork head domain transcription factor AFX1; Forkhead box protein O4; forkhead protein; FOX04b; FOXO4b; MGC120490; myeloid/lymphoid or mixed lineage-leukemia translocation to 7 homolog; myeloid/lymphoid or mixed-lineage leukemia (trithorax homolog, Drosophila); translocated to, 7; OTTHUMP00000023497; unnamed protein product
基因别名: AFX; AFX1; Afxh; Fkhr3; FOXO4; MLLT7; RGD1561201
UniProt ID: (Human) P98177, (Mouse) Q9WVH3
Entrez Gene ID: (Human) 4303, (Rat) 302415, (Mouse) 54601